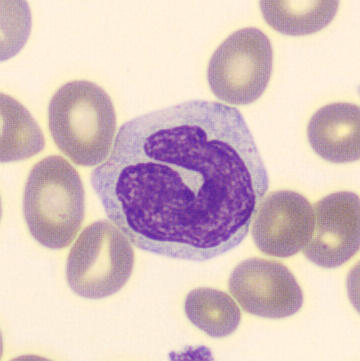

1/47
Looks like no tags are added yet.
Name | Mastery | Learn | Test | Matching | Spaced | Call with Kai |
|---|
No analytics yet
Send a link to your students to track their progress
Fluid connective tissue
Plasma (55%)
Ions, water (92%), proteins (7%) (albumins, globulins, fibrinogens), wastes, nutrients, hormones, vitamins, gases (N2, O2, CO2).
Formed Elements (45%)
Platelets (4.8%), RBCs (95.1%), WBCs (0.1%) (Neutrophils, eosinophils, basophils, monocytes, and lymphocytes)
Properties/Components of Blood
Transports nutrients, oxygen, carbon dioxide, waste and hormones.
Maintains homeostasis of interstitial fluid (fluid between cells).
Stabilizes body temperature. Absorbs and redistributes heat.
Travels through the circulatory system (heart and blood vessels).
Carries metabolic wastes to kidneys for excretion and transports specialized cells that defend tissue from infection and disease.
Prevents fluid losses through damaged vessels or at injury sites. Clotting reaction seals breaks in vessel walls.
Defend against toxins and pathogens (WBCs).
Functions of Blood
Plasma
The matrix that makes up 55% of blood. It is the liquid component of blood. Made of ions, water (92%), proteins (7%), wastes, nutrients, vitamins, hormones, electrolytes, and gases (N2, O2, CO2).
Albumins
A plasma protein that regulates osmosis (pull of water into blood). It is a contributor to osmotic pressure. Transports fatty acids, thyroid hormones, steroid hormones, and other substances. Makes up about 60% of plasma proteins.
Globulins
A plasma protein that carries around lipids and other non water soluble molecules (lipids, fats, steroids). It contains antibodies and aid in body defense. Makes up about 35% of plasma proteins.
Fibrinogen
A plasma protein that helps with blood clotting. It is the largest plasma protein. They interact, forming large, insoluble strands of fibrin (framework of blood clot). Makes up about 4% of plasma proteins.
Formed Elements
The blood cells and cell fragments that make up 45% of blood. It includes platelets, RBCs, and WBCs.

Erythrocytes (Red blood cells)
The formed elements that transport gases through the body (O2, CO2, NO). They are biconcave discs without a nucleus, mitochondria, ER, golgi, and vesicles. They are red in color due to hemoglobin molecules. Makes up about 95.1% of formed elements.
Biconcave disc, thin central region and thick outer margin.
Shape give the strength and flexibility. Bend and flex with ease.
Their ability to change shape allows cells to squeeze through small diameter, distorted, or compressed capillaries.
Shape also increases surface area that allows for faster gas diffusion.
No nucleus, mitochondria, ER, golgi, and vesicles.
Structure of Erythrocytes (RBCs)

Hemoglobin
The oxygen transport protein in RBCs. They make up 95% of erythrocytes proteins. Responsible for cells ability to transport oxygen and carbon dioxide. It is a globular protein that contains non protein red pigment. When oxygenated (iron binds to oxygen), they are a bright red color. And when deoxygenated (iron does not bind with oxygen), they are a deep red color. They have a complex shape that allows them to carry oxygen. Contain an iron group (heme) that binds to oxygen.

RBCs are produced in the red bone marrow.
Circulate for about 120 days.
Macrophages remove old RBCs and send the byproducts to the liver. Byproducts are released in the urine and feces.
Red Blood Cell Life Cycle

Anemia
A condition in which oxygen-carrying capacity of blood is reduced, diminishing delivery of oxygen to peripheral tissues. Some causes include iron deficiency, hemorrhage, hemolysis, etc..
Hematopoiesis
The development and formation of formed elements (RBCs, WBCs, and platelets). And red bone marrow is the primary site for blood cell formation.
Erythropoiesis
The production of erythrocytes. It begins in embryonic development and is regulated by erythropoietin.
Erythropoietin
The hormone produced by the kidney that promotes erythropoiesis. They live under low-oxygen conditions. Tells the bone marrow to produce more RBCs.
The processing of secreting erythropoietin is regulated through a negative feedback loop (helps maintain homeostasis).
Steps:
Low blood oxygen triggers erythropoietin secretion from kidneys.
Once erythropoietin is released, it travels to bone marrow and triggers production of RBCs.
This raises blood oxygen levels and so the kidneys will stop secretion.
Negative feedback loop = Raising oxygen levels, turns off the whole system.
2 effects:
Stimulates cell division rates in erythroblasts and in stem cells that produce them.
Speeds up maturation of RBCs, mainly by accelerating the synthesis.
Process of Erythropoiesis

Leukocytes (White blood cells)
The formed elements that are immune cells and protect against pathogens, remove toxins, wastes, or damaged cells. They are much larger than RBCs and are transported in the bloodstream to invading pathogens and damaged tissues. Makes up about 0.1% of formed elements.
Phagocytosis: WBCs engulf pathogens, form a vesicle around it and bring it inside its body, then the WBC will kill it, triggering an immune response.
They also produce chemicals or antibodies that attack pathogens.
Chemicals: Toxins, break down cell membrane of bacteria or breaks down viruses.
Antibodies: Chemicals that attack pathogens.
Functions of WBCs
Leukocyte Diapedesis
The process in which leukocytes can leave intact blood vessels by squeezing between cells. They can wander the body’s tissues to fight off pathogens. The WBC crosses the endothelial lining of a capillary by squeezing between adjacent endothelial cells.

Neutrophil
A type of white blood cell that is the most common. Its nucleus is dense and is arranged like beads on a string (3 lobes or more). It has pale and neutral color granules. Its main job is phagocytosis, attacks and digests bacteria. It also might use chemicals to kill pathogens. They have a short life span. So when they are bout to die, they will go to a pathogen and break its own cell open to release DNA that traps and captures any bacteria around. This is NETs. It basically commits suicide. Extra of these types of WBCs can indicate bacterial or viral infection.

Eosinophil
A type of white blood cell that has a bilobed, horse-shoe shape nucleus and red granules. They attack objects that are coated with antibodies. Release enzymes that release inflammation produced by mast cells and neutrophils, which controls the spread of inflammation to adjacent tissues. They prefer the use of chemicals to attack pathogens. They will attach to the pathogen and squirt out chemicals. Also occasionally do phagocytosis. These are seen in people with allergies or parasites.

Basophil
A type of white blood cell that has large dark blue/purple grains that makes the nucleus hard to see. It is very rare. They migrate to sites of injury and cross the capillary endothelium into the damaged or infected tissues. There, they release their granules into the interstitial fluid. They secrete chemicals which trigger inflammation. Chemicals include histamine, which dilates blood vessels and heparin, which prevent blood clots. These are seen in people who have allergies, they trigger signs of an allergic attack.
Monocyte
A type of white blood cell that is the largest. Its nucleus has a horse-shoe/kidney bean shape. It has tiny granules. They only do phagocytosis, no chemicals. Mature cells can leave blood through emigration and travel throughout the body. They become macrophages which destroy bacteria and are used to clean up dead cells and debris.

Lymphocyte
A type of white blood cells that is the smallest. It has a large and round nucleus with a little cytoplasm. They are responsible for specific immunity (ability of body to attack invading pathogens or foreign proteins on an individual basis). They use chemicals and antibodies to attack pathogens. Have different types: T-cells (enter peripheral tissues and attack foreign cells directly), B-cells (differentiate into plasma cells, secrete antibodies), NK (natural killer, destruct abnormal cells, immune surveillance, cells that target people with infected cells or cancers).
Leukocytosis
An elevated WBC count (acute infection or leukemia).
Leukopenia
A low WBC count (immune deficiency, typhoid, flu, or AIDS).
White Blood Cell Count
The total number of white blood cells.
Differential White Blood Cell Count
The comparison of percentages of white blood cells. They may give clues to help diagnose disease.
Eosinophilia: Too many eosinophil, indicates parasitic worm infection or allergies.
Neutrophilia: Too many neutrophil, indicates early stages of a bacterial infection.
Lymphocytosis: Too many lymphocytes, indicates viral or bacterial infection, cancer.
Examples of differential white blood cell counts

Thrombocytes (Platelets)
The formed elements that tiny flattened disc-shaped cells. They are membrane-enclosed packets of cytoplasm containing enzymes and clotting factors. They are continually replaced. Produced by megakaryocytes in red bone marrow. Aid in blood clotting (hemostasis). They have a short life span (10 days). And they are gobbled up by macrophages and their contents are recycled. Makes up about 4% of formed elements.
Thrombopoietin
A hormones that plays a crucial role in the regulation of platelet production.
Aid in blood clotting (hemostasis).
Initiate and control clotting process by releasing enzymes and other factors at appropriate times.
Clumping together at injury sites to form a platelet plug that slows the rate of blood loss while clotting occurs.
Containing actin and myosin filaments that interact and shorten during the clotting process. After blood clot is formed, the contraction of platelets shrinks the clot and pulls together the cut edges of the vessel wall.
Functions of Thrombocytes (platelets)

Megakaryocyte
Enormous cells with a dense, lobed/ring-shaped nucleus that form platelets by shedding cytoplasm. They eventually fragment and these fragments are the platelets. They manufacture structural proteins, enzymes, and membranes.
Hemostasis
Blood clotting (coagulation). It prevents the loss of blood through the walls of damaged vessels. Restricts blood loss, establishes framework for tissue repair. When platelets find a rough surfaces (at wounds) or when they are exposed to oxygen, they will release clotting factors which will trigger fibrinogen to unfold itself and form net that traps RBCs, they are sticky so platelets will stick too. This will trigger the process.
Platelet Plug Formation
Platelets stick to exposed collagen fibers, release factors, and recruit more platelets in the process if hemostasis.
Thrombus
A blood clot formed inside a blood vessel. Can block blood flow.
Embolus
A blood clot fragment traveling through the bloodstream and lodges in a blood vessel.
Infarction
An obstruction of the blood supply to an organ or region of tissue, typically by a thrombus of embolus, causing local death of the tissue.
Hemiagglutination/Agglutination
Blood clotting as a result of antibodies binding to the antigens on your red blood cells. It is the clumping of RBCs. Can occur if a patient has the wrong type of blood transfused into their body. The patients antibodies will bind to the donated blood and form clumps (can be fatal).
Antibodies
A plasma protein (immunoglobulin) that is part of the immune system. It binds to foreign antigens and ignores the body’s native antigens.
Antigens
Glycoproteins on the surface of a cell (A, B, Rh).
Type A Blood Group
A antigen, anti-B antibody
Type B Blood Group
B antigen, anti-A antibody
Type AB Blood Group
A and B antigens, no anti-A or B antibodies
Type O Blood Group
No A or B antigens, anti-A and B antibodies
Type Rh+ Blood Group
Has D or Rh antigens
Type Rh- Blood Group
Lacks D or Rh antigens
Hemolytic Disease of the Newborn
Process:
Rh- negative female with Rh- positive fetus.
Transfer of fetal Rh- positive cells during childbirth.
Mother becomes sensitized with Anti-Rh antibodies.
Subsequent Rh- positive pregnancy, maternal anitibodies attack fetal blood cells.
This puts the baby at high risk of diseases and even death.
Can be prevented with a drug called RhoGAM which binds to Rh antibodies and prevents them from attacking the fetus.